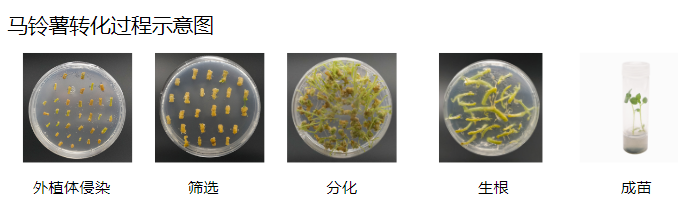
植物遗传转化一站式服务上线

植物遗传转化一站式服务上线
2025-12-11 13:23点击次数:48
关键词:植物遗传转化、一站式技术服务、CRISPR/Cas9、稳定转化材料、阳性鉴定水稻/拟南芥/番茄遗传转化、载体构建、PCR/qPCR鉴定、编辑位点测序亚细胞定位、共聚焦成像、蛋白互作验证(CoIP/BiFC/EMSA)、功能基因研究植物遗传转化是功能基因研究、性状改良、抗逆机理解析及基因编辑验证的关键技术路径。但对多数课题组而言,稳定转化周期长、节点多、变量多:从载体构建、体系选择,到再生筛选、阳性鉴定、位点确认与后续机制实验衔接,往往会消耗大量时间与人力。
为帮助高校与科研院所显著缩短实验周期、提升验证闭环效率,擎科生物推出「植物遗传转化与下游验证一站式服务」:覆盖多物种遗传转化、稳定材料交付、PCR/qPCR/测序鉴定,并可与亚细胞定位、互作验证、分型测序等服务联用,快速补齐证据链。
你只需要提供
-
目标基因/靶点信息与实验目的:过表达(OE)/ 干扰(RNAi)/ CRISPR 编辑等
-
物种与品种/品系背景信息(如有特定筛选策略、标记偏好请说明)
-
如已有构建完成载体,可直接进入转化环节
我们交付什么
-
项目方案设计与流程确认(关键节点清晰、交付物明确)
-
(可选)工程载体构建:质粒图谱 + 测序结果
-
稳定遗传转化材料交付(代次、数量、筛选策略按项目方案约定)
-
阳性鉴定与位点确认:PCR / qPCR / 编辑位点测序等(按方案执行)
-
(可选)下游应用验证支持:为定位、互作、分型、测序等实验提供材料或技术路径建议,帮助实验快速衔接推进
覆盖物种与服务方向
-
水稻遗传转化(稳定材料交付,含阳性鉴定)https://www.biomart.cn/infosupply/117968367.htm
-
拟南芥遗传转化(OE / RNAi / 启动子报告 / CRISPR 编辑等)https://www.biomart.cn/infosupply/117968375.htm
-
番茄遗传转化(再生筛选 + 阳性鉴定 + 位点确认)https://www.biomart.cn/infosupply/117968381.htm
-
烟草遗传转化(定位/互作/机制验证常用体系)https://www.biomart.cn/infosupply/117968385.htm
-
大豆遗传转化(育种相关验证与编辑验证场景)https://www.biomart.cn/infosupply/117968388.htm
-
马铃薯遗传转化(块茎/代谢研究与性状改良验证)https://www.biomart.cn/infosupply/117968392.htm
-
杨树遗传转化(木本植物发育/抗逆与编辑验证)https://www.biomart.cn/infosupply/117968396.htm
同时支持与以下下游模块联用:
-
亚细胞定位(共聚焦成像交付)https://www.biomart.cn/infosupply/117968402.htm
-
互作验证(如 CoIP、BiFC 等思路支持/材料对接)
-
分型与测序(如 KASP 分型、编辑位点测序、液相芯片测序等)
典型交付物长什么样
以下图片为通用原理/过程示意图或典型结果样式说明,并非具体项目数据;实际以擎科生物服务交付为准。

适用单位与对接方式(高校/科研院所一对一服务)
擎科覆盖全国多区域服务网络,可按单位所在地与研究方向匹配专属销售/技术支持。
请在咨询/留言中说明以下信息,我们将安排对应同事一对一对接:
-
单位 + 城市
-
物种/体系
-
目的(OE / 编辑 / 定位 / 验证)
-
预计样本量/交付期望
-
是否已有载体(如有可直接进入转化环节)

本周
本月
本年
LetPub发布最新SCI影响因子查询及期刊投稿分析系统
ELISpot试剂盒限时特惠!一口价低至500元,加赠免费读板服务
草甘膦(glyphosate)酶联免疫分析(ELISA)试剂盒使用说明书
应用gentleMACS™灌流技术从脂肪肝小鼠模型高效分离肝细胞与非实质细胞
单个细胞也能提取核酸?超全干货教你微量样本发高分(含完整电子版宝典资料))
链脲佐菌素 (Streptozotocin,STZ)-糖尿病动物模型造模
LetPub完整SCI影响因子、期刊分区查询系统
研究思路 | 多组学专题——如何进行转录组+蛋白组关联分析?
Elabscience® 从原料到标记,打造属于中国自己的流式抗体品牌
淋巴细胞百分比偏低原因解析
- 促销公告
- 更多 ›


